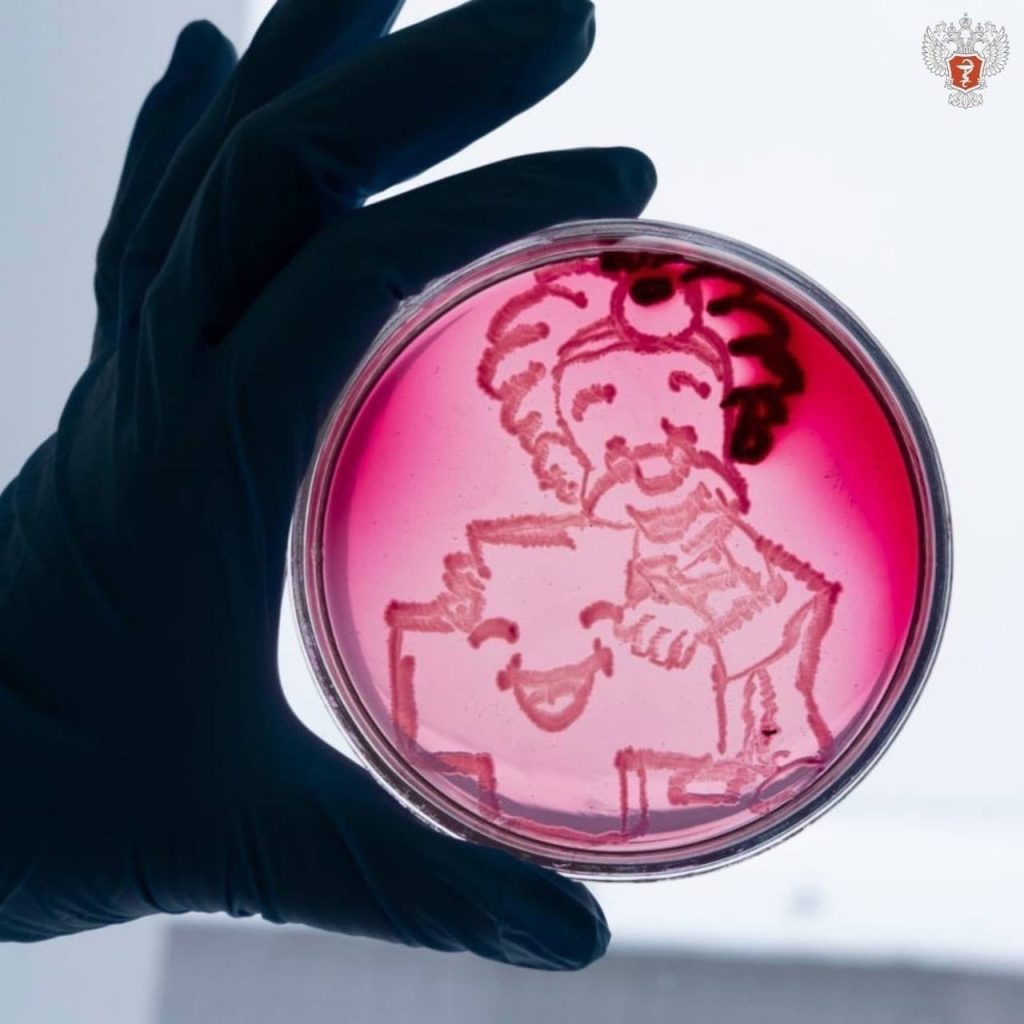

Необычным творчеством занимаются студенты-медики на кафедре микробиологии КемГМУ. Нарисовать бактериями можно что угодно: узор, портрет, натюрморт, пейзаж и даже репродукции картин. Чтобы получился рисунок, необходимо знать особенности каждого микроорганизма, чтобы спрогнозировать, в какой именно цвет будут окрашены колонии, как они будут выглядеть. Только в этом случае получится рисунок. Целые сутки, пока чашки стоят в термостате, автор не знает, получилась ли его задумка. Результат зависит от поведения самих бактерий: если они не будут размножаться или, наоборот, займут собой всю чашку, картина не получится. Знания о посеве бактерий, о том, как их выращивать, необходимы для того, чтобы уметь идентифицировать вид бактерий. В медицинской практике это позволяет поставить диагноз при инфекционных заболеваниях, организовать мероприятия по дезинфекции или выяснить, какие микроорганизмы могут выживать в тех или иных условиях.





